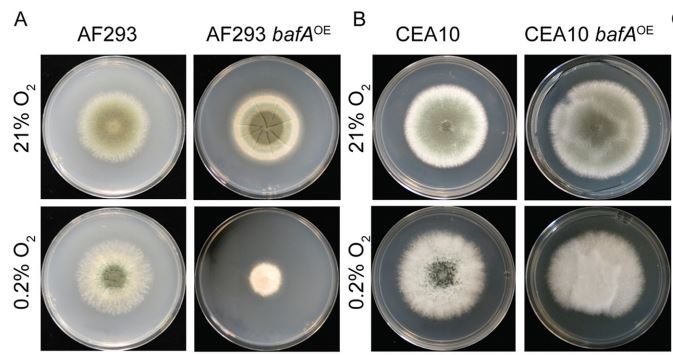
mBio (@mbiojournal) on Twitter photo A Heterogeneously Expressed Gene Family Modulates the Biofilm Architecture and Hypoxic Growth of Aspergillus fumigatus skyw.io/bfMi2Z A Heterogeneously Expressed Gene Family Modulates the Biofilm Architecture and Hypoxic Growth of Aspergillus fumigatus skyw.io/bfMi2Z

Microbial Immunology
@hki_mi
We investigate interactions between #Candida, the #microbiota, and the #host, aiming to understand what leads to pathogenicity
ID: 1044577341437923331
https://www.leibniz-hki.de/en/mikrobielle-immunologie.html 25-09-2018 13:20:20
139 Tweet
343 Followers
77 Following







Further support to fight pathogenic fungi: TRR 124 FungiNet receives funding from DFG public | @[email protected] for a third period. Scientists from Peter W, @Uni_Wue and the @Leibniz-HKI will expand and deepen research on infection mechanisms and new therapy options.

We're looking forward to four more years of exciting and important research on human pathogenic fungi with our partners in TRR 124 FungiNet Universität Jena Universität Würzburg #UniWürzburg DFG public | @[email protected] 🎉

Metabolic change: Non filamentous Candida albicans mutant is still highly virulent. Great work in a great team TRR 124 FungiNet by first author Christine Dunker Microbial Immunology, Universität Jena, Ilse Jacobsen, Thomas Dandekar Universität Würzburg #UniWürzburg and @swidergall_lab. nature.com/articles/s4146…




The Leibniz-HKI and kuenstlerische_tatsachen worked hard to fuse #science and #art together. The exibition can now be seen at Trafo here in Jena. Our group collaborated with #MasamiSaito to create some unique intestinal microbiota sculptures. Go check it out.


My PhD Project just became a carped. Thanks to #AndreaGarciaVasquez from kuenstlerische_tatsachen Microbial Immunology